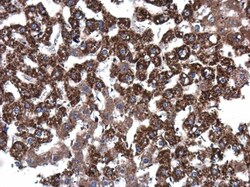
Invitrogen Epo Polyclonal Antibody 100 &mu;L; Unconjugated:Antibodies

missing translation for 'onlineSavingsMsg'
Learn More
Learn More
Invitrogen™ Epo Polyclonal Antibody


Rabbit Polyclonal Antibody
Marca: Invitrogen™ PA585107
Questo articolo non è restituibile.
Consulta la politica di reso
Descrizione
Keep as concentrated solution. Predicted reactivity: Rat (80%), Dog (80%), Cat (82%), Pig (81%), Rabbit (80%), Sheep (81%), Rhesus Monkey (89%), Bovine (80%). Positive Control: rPT EPO. Store product as a concentrated solution. Centrifuge briefly prior to opening the vial.
Erythropoietin (EPO) protein is a growth factor essential for the survival, proliferation, and differentiation of erythroid precursors. EPO is not responsible for early commitment to the lineage, and instead induces the final maturation of partially differentiated erythroid cells and the production of red cell-specific proteins, such as hemoglobin. The EPO receptor (EPOR) is present in higher levels on precursor cells, and expression diminishes with cell maturation.Hepatocytes are the main source of EPO in the fetus, followed by interstitial cells of the kidney after birth and through adulthood. EPO expression is upregulated during hypoxia, and low levels of transcription have also been detected in lung and brain tissue under these conditions. Recent data suggest that EPO may also play a role in the protection of neuronal tissue from damage and initiation of repair.
Specifica
| Epo | |
| Polyclonal | |
| Unconjugated | |
| EPO | |
| EP; EPO; Epoetin; erythropoietin; MGC138142; MVCD2 | |
| Rabbit | |
| Antigen affinity chromatography | |
| RUO | |
| 2056, 24335 | |
| Store at 4°C short term. For long term storage, store at -20°C, avoiding freeze/thaw cycles. | |
| Liquid |
| ELISA, Immunohistochemistry (Paraffin), Western Blot | |
| 0.62 mg/mL | |
| PBS with 20% glycerol and 0.025% ProClin 300; pH 7 | |
| P01588, P29676 | |
| EPO | |
| Recombinant protein encompassing a sequence within the center region of human EPO. The exact sequence is proprietary. | |
| 100 μL | |
| Primary | |
| Human, Rat | |
| Antibody | |
| IgG |
Correzione del contenuto del prodotto
Fornite il vostro feedback sul contenuto del prodotto compilando il modulo sottostante.
Titolo del prodotto
Individuate un'opportunità di miglioramento?Condividi una correzione di contenuto